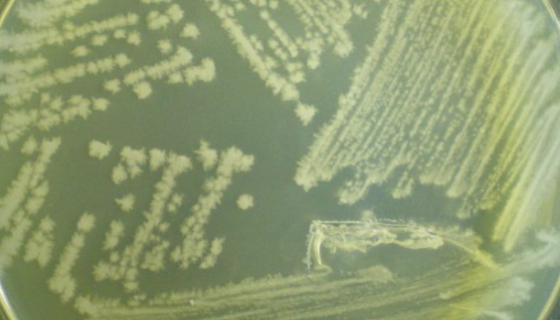
耐盐芽孢杆菌——产β-半乳糖苷酶和木聚糖酶
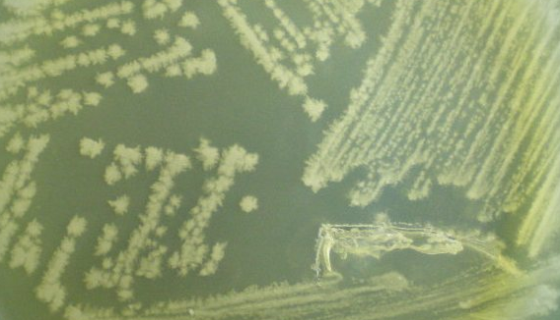
坚强芽孢杆菌的应用发明及学术与文献研究！
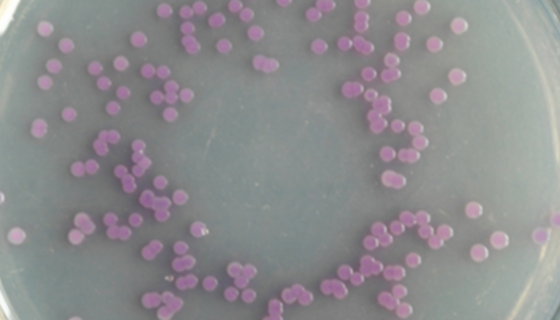
需钠弧菌的储存条件与培养条件及注意事项！

甲烷菌的特性与作用及生存环境与测定方法!
甲烷菌属于原核生物,是专性严格厌氧菌、生长繁殖特别缓慢、培养...
耐盐芽孢杆菌——产β-半乳糖苷酶和木聚糖酶
耐盐芽孢杆菌是Bacillus属的微生物,原产地为中国。革兰...

毒蝇鹅膏菌的形态特征与地理分布及分类变种!
毒蝇鹅膏菌,层菌纲伞菌目真菌,称哈蟆菌、捕蝇菌、毒蝇菌、毒蝇...
坚强芽孢杆菌的应用发明及学术与文献研究!
坚强芽孢杆菌用于实验和科研检测用,属于菌株类。

脐带间充质干细胞的分离培养及用途与研究!
脐带间充质干细胞(Mesenchymal Stem Cell...

小肠结肠炎耶尔森菌——喜冷低温菌
小肠结肠炎耶尔森菌是一种人兽共患细菌,在动物界它可感染家畜(...

丁酸梭菌作为添加剂在饲料中的作用有哪些?
丁酸梭菌属于芽孢杆菌科,梭菌属,革兰氏阳性,有芽孢,孢子卵圆...
需钠弧菌的储存条件与培养条件及注意事项!
需钠弧菌属于菌株类。革兰氏阴性细菌,兼性厌氧,呼吸和发酵代谢...

大豆茎溃疡病菌的生物特性与传染途径及防疫方法!
大豆北方茎溃疡病菌主要发生于巴西、阿根廷、意大利、法国、俄罗...